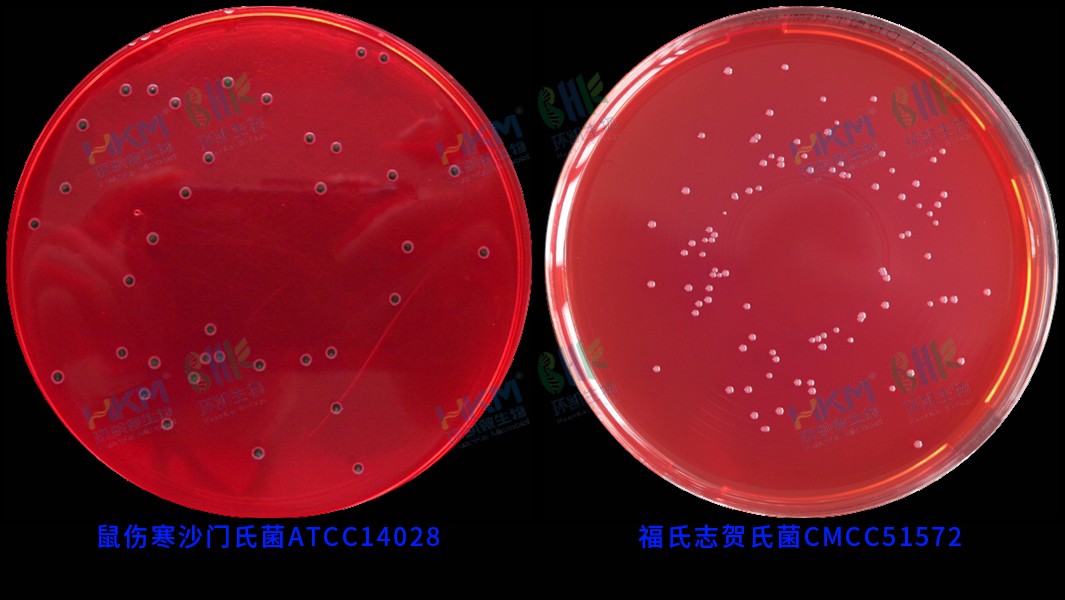
029999 XLD琼脂培养基(GB沙门) 鼠伤寒沙门氏菌ATCC14028 及 福氏志贺氏菌CMCC(B)51572 反应特征

商品详细
说明书
微生物图册
行业应用
相关论文
通用名称:木糖赖氨酸脱氧胆盐(XLD)琼脂
英文名称:Xylose Lysine Desoxycholate Agar
通常叫法:木糖赖氨酸脱氧胆盐琼脂培养基
产品编号与包装规格:
| 产品编号 | 产品类型 | 包装规格 |
|---|---|---|
| 029999 | 干粉 | 250g/瓶 |
产品用途:用于沙门氏菌、志贺氏菌的分离培养。
检验原理:酵母浸粉提供氮源、维生素、生长因子; 氯化钠维持均衡的渗透压;木塘、乳糖、蔗糖为可发酵糖类,产酸使酚红指示剂变黄;去氧胆酸钠抑制革兰氏阳性菌,但不影响沙门氏菌的生长;硫代硫酸钠可被某些细菌还原硫化氢,与柠檬酸铁铵中的铁盐生成黑色硫化铁;琼脂是培养基的凝固剂;酚红为pH指示剂。
XLD琼脂培养基(GB沙门)配方成分:
| 配方(每升) | 含量 |
|---|---|
| 酵母浸粉 | 3.0g |
| L-赖氨酸 | 5.0g |
| 木糖 | 3.75g |
| 乳糖 | 7.5g |
| 蔗糖 | 7.5g |
| 氯化钠 | 5.0g |
| 硫代硫酸钠 | 6.8g |
| 脱氧胆酸钠 | 2.5g |
| 柠檬酸铁铵 | 0.8g |
| 酚红 | 0.08g |
| 琼脂 | 15.0g |
| 最终pH 7.4±0.2 | |
使用方法:称取本品56.9g,加入蒸馏水或去离子水1 L,搅拌加热煮沸至完全溶解,分装三角瓶,无需高压灭菌,待冷却至48℃±2℃倾注无菌平板,备用。
XLD琼脂培养基(GB沙门)质量控制(下列质控菌株接种待测试培养基, 35~37℃,24h结果如下:)
| 指标 | 质控菌株及编号 | 标准值 | 特征性反应 |
|---|---|---|---|
| 生长率 | 福氏志贺氏菌CMCC(B)51572 | PR≥0.5 | 红色菌落,无黑心 |
| 鼠伤寒沙门氏菌ATCC14028 | PR≥0.7 | 红色菌落,有黑心 | |
| 特异性 | 大肠埃希氏菌ATCC25922 | G<5 | — |
| 选择性 | 金黄色葡萄球菌ATCC6538 | G≤1 | — |
储存条件与保质期:贮存于避光、干燥处,用后立即旋紧瓶盖;贮存期三年。
参考文献:GB 4789.4-2024 食品安全国家标准 食品微生物学检验 沙门氏菌检验
029999 XLD琼脂培养基(GB沙门) 250g/瓶 相关产品(用于沙门氏菌检验):
| 产品名称 | 产品货号 | 产品类型 | 规格 | 产品说明及用途 |
| DHL琼脂(胆硫乳琼脂) | 023060 | 干粉 | 250g/瓶 | 用于肠道致病菌特别是沙门氏菌和志贺氏菌的选择性分离培养(GB) |
| dhl琼脂平板 | 023065 | 成品平板 | 90mm×20个 | |
| HE琼脂培养基 | 023070 | 干粉 | 250g/瓶 | 用于肠道致病菌特别是沙门氏菌和志贺氏菌的选择性分离培养(GB4789.4和SN/T220) |
| HE琼脂颗粒培养基 | 023070P1 | 颗粒 | 250g/瓶 | |
| HE琼脂平板 | CP0110 | 成品平板 | 90mm×20个 | |
| SS琼脂培养基 | 023080 | 干粉 | 250g/瓶 | 用于沙门氏菌和某些志贺氏菌的选择性分离培养。(SN/T2206.1) |
| SS琼脂平板培养基 | 024077 | 成品平板 | 90mm×20个 | |
| 酚红煌绿琼脂 | 023110 | 干粉 | 250g/瓶 | 用于分离培养沙门氏菌(伤寒沙门氏菌除外)。(GB13091-91) |
| 中国蓝琼脂培养基 | 023115 | 干粉 | 250g/瓶 | 用于肠道菌的弱选择性分离培养。 |
| 中国蓝琼脂平板 | CP0090 | 成品平板 | 90mm×20个 | |
| 中国蓝琼脂培养基(红色配方) | 023115T2 | 干粉 | 250g/瓶 | 用于肠道菌的弱选择性分离。 |
| 沙门氏菌鞭毛诱导软琼脂 | 023118 | 干粉 | 250g/瓶 | 用于沙门氏菌鞭毛的诱导。 |
| 三糖铁(TSI)琼脂培养基 | 022080 | 干粉 | 250g/瓶 | 用于鉴别肠道菌发酵蔗糖、乳糖、葡萄糖及产生硫化氢的生化反应。(GB4789.4) |
| 三糖铁琼脂斜面(TSI) | CP0080 | 管装成品 | 10mL×20支 | |
| 沙门氏菌显色培养基 | CRM004 | 干粉 | 1000mL/瓶 | 用于沙门氏菌的分离和初步鉴定 |
| 沙门氏菌显色培养基平板 | CP0560 | 成品平板 | 90mm×20个 | |
| EasyID沙门氏菌生化鉴定试剂盒 | HKI002 | 试剂盒 | 11项×10套 | 用于沙门氏菌13项生化反应 |
| 沙门氏菌核酸检测试剂盒(PCR-荧光探针法) | FZ005BF2 | 分子试剂盒 | 48test | 用于食品中沙门氏菌的检测 |
| RV沙门菌增菌液体培养基(20版药典) | 023022 | 干粉 | 250g/瓶 | 用于沙门氏菌选择性增菌培养。(20版CP、USP) |
| RV沙门菌增菌液体培养基(颗粒型)(20版药典) | 023022P1 | 颗粒 | 250g/瓶 | |
| RV沙门菌增菌液体培养基(管装成品)(20版药典) | CP3022G1 | 管装成品 | 10mL×20支 | |
| 木糖赖氨酸脱氧胆酸盐琼脂培养基(20版药典) | 029997 | 干粉 | 250g/瓶 | 用于药品中沙门氏菌的选择分离培养。(中国药典2020年版) |
| XLD琼脂培养基(颗粒性)(20版药典) | 029997P1 | 颗粒 | 250g/瓶 | |
| XLD琼脂平板培养基(20版药典) | CP9997B1 | 成品平板 | 90mm×10个 | |
| 三糖铁琼脂培养基(TSI)(药典) | 022081 | 干粉 | 250g/瓶 | 用于鉴别肠道菌发酵蔗糖、乳糖、葡萄糖及产生硫化氢的生化反应。(20版药典) |
| 三糖铁琼脂颗粒型培养基(药典) | 022081P1 | 颗粒 | 250g/瓶 | |
| 三糖铁琼脂斜面培养基(TSI)(药典) | CP22081G1 | 管装成品 | 10mL×20支 | |
| 沙门、志贺菌属琼脂培养基(SS)(药典) | 023081 | 干粉 | 250g/瓶 | 用于沙门氏菌和某些志贺氏菌的选择性分离培养。(《中华人民共和国药典》2010年版) |
| 胆盐硫乳琼脂培养基(DHL)(药典) | 023062 | 干粉 | 250g/瓶 | 用于肠道致病菌特别是沙门氏菌和志贺氏菌的选择性分离培养(药典) |
| 缓冲蛋白胨水(BPW) | 023130 | 干粉 | 250g/瓶 | 用于食品中沙门氏菌和阪崎肠杆菌的前增菌培养。(GB 4789.4、GB 4789.40) |
| 缓冲蛋白胨水瓶装颗粒培养基(BPW) | 023130P1 | 颗粒 | 250g/瓶 | |
| 缓冲蛋白胨水(BPW)(225mL袋装) | CP0680 | 袋装成品 | 225mL×10袋 | |
| 缓冲蛋白胨水(BPW)(225mL瓶装) | CP0290 | 瓶装液体 | 225mL×10瓶 | |
| 缓冲蛋白胨水(BPW)(管装成品) | CP0560A | 管装成品 | 9mL×20支 | |
| 氯化镁孔雀绿增菌液(MM) | 023020 | 干粉 | 250g/瓶 | 用于食品和环境样本中沙门氏菌的选择性增菌培养。 |
| 乳糖肉汤(LB)培养基 | 023137 | 干粉 | 250g/瓶 | 用于沙门氏菌前增菌培养。(FDA) |
| GN增菌液 | 023140 | 干粉 | 250g/瓶 | 用于革兰氏阴性菌的选择性培养,特别是志贺氏菌和沙门氏菌的增菌培养(GB/T4789.5、GB/T4789.28) |
| GN增菌液 (管装成品) | 23140G1 | 管装成品 | 10mL×20支 | |
| GN增菌液 | CP0550 | 瓶装液体 | 225mL×10瓶 | |
| GN增菌液 | CP0650 | 袋装成品 | 225mL×10袋 | |
| 双料GN增菌液 | C23140P2 | 瓶装液体 | 100mL/瓶 | |
| 亚硒酸盐增菌液(SF) | 023041 | 干粉 | 100g/瓶 | 用于污水和污泥中沙门氏菌的选择性增菌。(GB18466) |
| SF增菌液 (10mL管装成品) | CP0330A | 管装成品 | 10mL×20支 | |
| 双料亚硒酸盐增菌液(SF) | C23041P1 | 瓶装液体 | 100mL/瓶 | |
| 亚硒酸盐胱氨酸增菌液(SC) | 023040 | 干粉 | 250g/瓶 | 用于沙门氏菌选择性增菌培养。(GB 4789.4) |
| 亚硒酸盐胱氨酸增菌 颗粒性培养基(SC) | 023040P1 | 颗粒 | 250g/瓶 | |
| SC增菌液(10mL管装成品) | CP0050 | 管装成品 | 10mL×20支 | |
| 四硫磺酸钠煌绿增菌液基础(TTB) | 023030 | 干粉基础 | 250g/瓶 | 用于沙门氏菌选择性增菌培养。(GB 4789.4) |
| 四硫磺酸盐煌绿增菌液(TTB) | 023030B | 瓶装液体 | 250mL/瓶 | |
| 四硫磺酸盐煌绿增菌液(TTB) | CP0300 | 管装成品 | 10mL×20支 | |
| Muller-Kauffmann氏四硫磺酸钠肉汤基础 | 023032 | 干粉基础 | 250g/瓶 | 用于羽绒羽毛中沙门氏菌选择性培养 |
| 改良亚硒酸盐磺绿增菌肉汤培养基(SBG增菌液) | 023043 | 干粉 | 250g/瓶 | 用于沙门氏菌选择性增菌培养。 |
| SBG增菌液(5mL管装成品) | CP0810G | 管装成品 | 5mL×20支 | |
| MKTTn肉汤基础培养基 | 023033 | 干粉基础 | 250g/瓶 | 用于沙门氏菌选择性增菌培养。(ISO) |
| MKTTn肉汤培养基(ISO) | C23033G1 | 管装成品 | 10mL×20支 | |
| 改良MSRV培养基琼脂基础(半固体) | 023025 | 干粉基础 | 250g/瓶 | 用于分离游动性沙门氏菌 (Merck方法) |
| XLT-4琼脂基础 | 029996 | 干粉基础 | 250g/瓶 | 用于非伤寒沙门氏菌的选择性分离培养。 |
| XLT-4琼脂平板 | CP0180B | 成品平板 | 90mm×20个 | |
| 亚硫酸铋(BS)琼脂培养基 | 023052 | 干粉 | 250g/瓶 | 用于沙门氏菌特别是伤寒沙门氏菌的选择性分离培养(GB4789.4) |
| BS琼脂平板(保质期1个月) | 022547C | 成品平板 | 90mm×20个 |
本产品仅限于科研研究用途,不能用于医院和临床检测,购买者请知悉!
